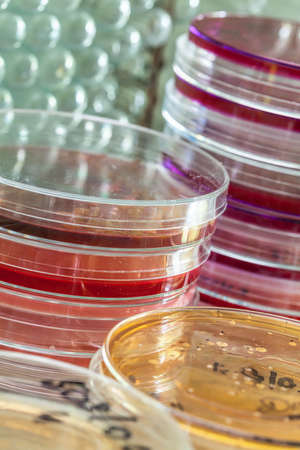
Colourful petri dishes in laboratory in front of the test tubesの写真素材

写真素材 - Colourful petri dishes in laboratory in front of the test tubes
作品情報
Colourful petri dishes in laboratory in front of the test tubes
- ID:22104985
- 作品種別:写真
- 作者名:Katarzyna Białasiewicz
キーワード
- academic
- accomplishment
- achievement
- agar plate
- analyse
- analysis
- apparatus
- bacteria
- biochemical
- biochemistry
- biology
- biotope
- blood
- cellar
- cellars
- chemical
- chemistry
- colourful
- discovery
- drug
- education
- educational
- educative
- glass
- glasses
- health
- healthy
- lab
- labor
- laboratory
- liquid
- medical
- medicine
- mycobacterium tuberculosis
- progress
- reaction
- research
- science
- scientific
- serum
- substance
- technology
- test
- test tube
- testing
- toxin
- tube
- tubes
- vibrio cholerae
- petri dish
類似作品
Petri dishes wi...
Pink, blue and ...
Gloved hands of...
Laboratory tech...
Pyramids from P...
Biochem test ki...
Oil bubbles pai...
science and cli...
Test tubes on a...
a glass vessel ...
Petri dishes wi...
Tower of petri ...
Petri dishes wi...
Various colorfu...
Set of Petri di...
Pipette with dr...
laboratory glas...
Herbal leaf in ...
several tubes w...
Stack of petri ...
Petri dishes wi...
Lab glassware o...
Empty colored p...
Concept of scie...
Pipette with dr...
Glitter bubbles...
color liquid in...
Laboratory tech...
Close-up of Pet...
Hair dye kit , ...
The texture of ...
Petri dishes wi...
Bacterial cultu...
E. coli growing...
Scientist Works...
Making herbal d...
Laboratory glas...
Test tubes with...
Colorful fluid ...
Close up of lit...
Petri dishes wi...
Colorful fluid ...
E coli bacteria...
Professional do...
Bacterial cultu...
Gel candle in g...
Petri dishes wi...
Laboratory Equi...
E. coli growing...